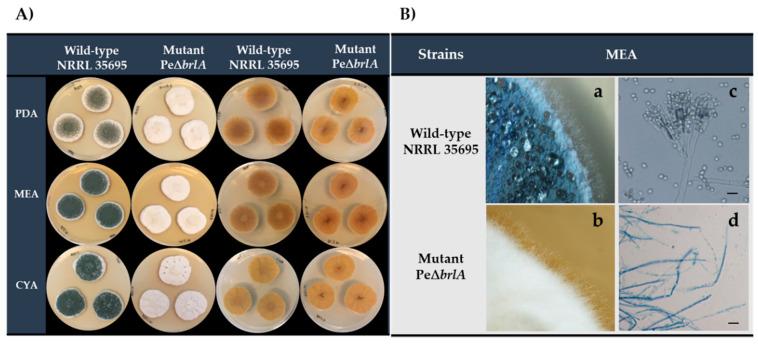
https://cdn.ncbi.nlm.nih.gov/pmc/blobs/3f17/7555563/6f50c9b6dd31/ijms-21-06660-g001.jpg

基因缺失揭示展青霉素生物合成与无性生殖无关。
The Gene Deletion Reveals That Patulin Biosynthesis Is Not Related to Conidiation in .
机构信息
Toxalim (Research Centre in Food Toxicology), Université de Toulouse, INRAE, ENVT, INP-Purpan, UPS, 31027 Toulouse, France.
出版信息
Int J Mol Sci. 2020 Sep 11;21(18):6660. doi: 10.3390/ijms21186660.
Dissemination and survival of ascomycetes is through asexual spores. The gene encodes a CH-type zinc-finger transcription factor, which is essential for asexual development. causes blue mold disease and is the main source of patulin, a mycotoxin that contaminates apple-based food. A PeΔ deficient strain was generated by homologous recombination. In vivo, suppression of completely blocked the development of conidiophores that takes place after the formation of coremia/synnemata, a required step for the perforation of the apple epicarp. Metabolome analysis displayed that patulin production was enhanced by suppression, explaining a higher in vivo aggressiveness compared to the wild type (WT) strain. No patulin was detected in the synnemata, suggesting that patulin biosynthesis stopped when the fungus exited the apple. In vitro transcriptome analysis of PeΔ unveiled an up-regulated biosynthetic gene cluster (PEXP_073960-PEXP_074060) that shares high similarity with the chaetoglobosin gene cluster of . Metabolome analysis of PeΔ confirmed these observations by unveiling a greater diversity of chaetoglobosin derivatives. We observed that chaetoglobosins A and C were found only in the synnemata, located outside of the apple, whereas other chaetoglobosins were detected in apple flesh, suggesting a spatial-temporal organization of the chaetoglobosin biosynthesis pathway.
子囊菌通过无性孢子进行传播和生存。该基因编码一种 CH 型锌指转录因子,对于无性发育至关重要。它会导致青霉病,也是棒曲霉素(一种污染苹果制品的真菌毒素)的主要来源。通过同源重组生成了一个缺失的突变株。在体内,对的抑制完全阻止了在核心体/联体形成后发生的分生孢子梗发育,这是穿透苹果外果皮所必需的步骤。代谢组学分析显示,与野生型(WT)菌株相比,抑制作用增强了棒曲霉素的产生,解释了其更高的体内侵袭性。在联体中未检测到棒曲霉素,表明当真菌离开苹果时,棒曲霉素生物合成停止。PeΔ 的体外转录组分析揭示了一个上调的生物合成基因簇(PEXP_073960-PEXP_074060),与的 chaetoglobosin 基因簇具有高度相似性。PeΔ 的代谢组学分析通过揭示更多 chaetoglobosin 衍生物证实了这些观察结果。我们观察到 chaetoglobosins A 和 C 仅存在于联体中,位于苹果外部,而其他 chaetoglobosins则存在于苹果果肉中,这表明 chaetoglobosin 生物合成途径存在时空组织。